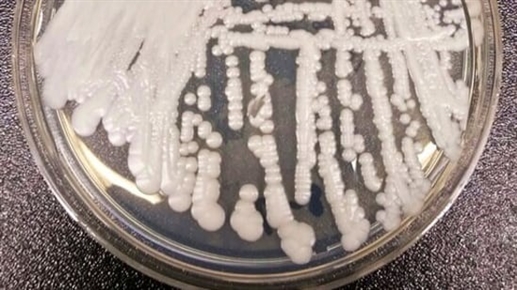

ਕੈਂਡਿਡਾ ਔਰਿਸ ਯੀਸਟ ਦਾ ਇਕ ਖ਼ਤਰਨਾਕ ਰੂਪ ਹੈ। ਇਸ ਨੂੰ ਗੰਭੀਰ ਮੈਡੀਕਲ ਕੰਡੀਸ਼ਨ ਵਾਲੇ ਰੋਗੀਆਂ ਲਈ ਬੇਹੱਦ ਖ਼ਤਰਨਾਕ ਮੰਨਿਆ ਜਾਂਦਾ ਹੈ ਕਿਉਂਕਿ ਇਹ ਖ਼ੂਨ ਦੇ ਪ੍ਰਵਾਹ ‘ਚ ਇਨਫੈਕਸ਼ਨ ਤੇ ਇੱਥੋਂ ਤਕ ਕਿ ਮੌਤ ਦੀ ਵਜ੍ਹਾ ਵੀ ਬਣ ਸਕਦਾ ਹੈ।
CDC ਦੀ ਮੇਘਨ ਰਿਆਨ ਨੇ ਕਿਹਾ ਕਿ ਉਹ ਪਹਿਲੀ ਵਾਰ ਕੈਂਡਿਡਾ ਔਰਿਸ ਦੇ ਕਲੱਸਟਰ ਨੂੰ ਦੇਖ ਰਹੀ ਹੈ ਜਿਸ ਵਿਚ ਮਰੀਜ਼ ਇਕ-ਦੂਸਰੇ ਤੋਂ ਇਨਫੈਕਟਿਡ ਹੋ ਰਹੇ ਹਨ। ਵਾਸ਼ਿੰਗਟਨ ਡੀਸੀ ਨਰਸਿੰਗ ਹੋਮ ‘ਚ ਕੈਂਡਿਡਾ ਔਰਿਸ ਦੇ 101 ਮਾਮਲੇ ਰਿਪੋਰਟ ਕੀਤੇ ਗਏ, ਇਸ ਵਿਚੋਂ ਤਿੰਨ ਅਜਿਹੇ ਮਾਮਲੇ ਸਨ ਜਿਹੜੇ ਹਰ ਤਿੰਨ ਪ੍ਰਕਾਰ ਦੀ ਐਂਟੀਫੰਗਲ ਦਵਾਈਆਂ ਖਿਲਾਫ਼ ਪ੍ਰਤੀਰੋਧੀ ਸਨ। ਉੱਥੇ ਹੀ ਡਲਾਸ ਖੇਤਰ ਦੇ ਦੋ ਹਸਪਤਾਲਾਂ ‘ਚ ਕੈਂਡਿਡਾ ਔਰਿਸ ਦੇ 22 ਮਾਮਲਿਆਂ ਦਾ ਕਲੱਸਟਰ ਰਿਪੋਰਟ ਕੀਤਾ ਗਿਆ। ਦੋ ਮਾਮਲੇ ਮਲਟੀਡਰੱਗ ਪ੍ਰਤੀਰੋਧੀ ਪਾਏ ਗਏ। CDC ਇਸ ਸਿੱਟੇ ‘ਤੇ ਪੁੱਜਾ ਹੈ ਕਿ ਇਹ ਇਨਫੈਕਸ਼ਨ ਮਰੀਜ਼ਾਂ ਤੋਂ ਮਰੀਜ਼ਾਂ ‘ਚ ਫੈਲ ਰਿਹਾ ਹੈ। ਇਹ 2019 ਦੇ ਉਲਟ ਹੈ, ਜਦੋਂ ਵਿਗਿਆਨੀਆਂ ਨੇ ਨਤੀਜਾ ਕੱਢਿਆ ਕਿ ਇਲਾਜ ਦੌਰਾਨ ਨਿਊਯਾਰਕ ‘ਚ ਤਿੰਨ ਮਰੀਜ਼ਾਂ ‘ਚ ਦਵਾਈਆਂ ਦਾ ਰਿਐਕਸ਼ਨ ਬਣਿਆ।